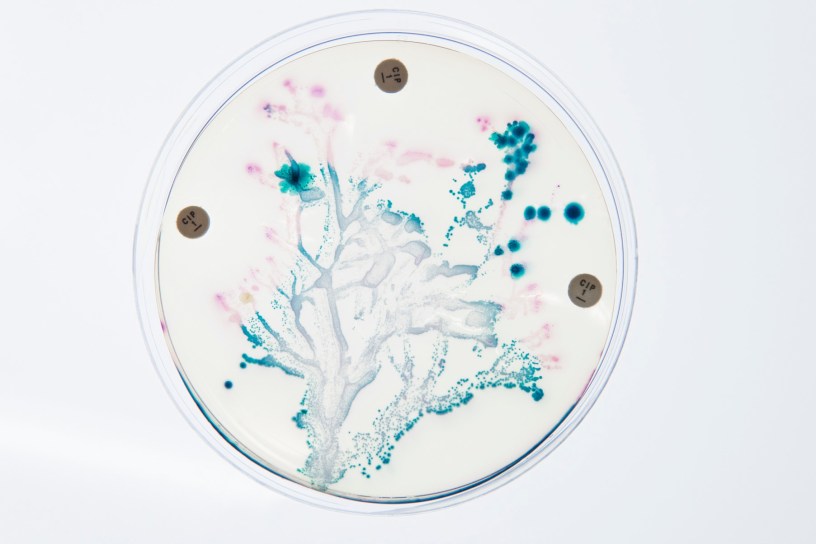

There’s nothing more festive than helping those in need, and that’s exactly what Bash the Bug is focused on doing. Tuberculosis kills millions of people worldwide every year. This project aims to understand resistance of the bacteria to antibiotics so that treatment can be made more effective. Help out now at www.zooniverse.org/projects/mrniaboc/bash-the-bug.